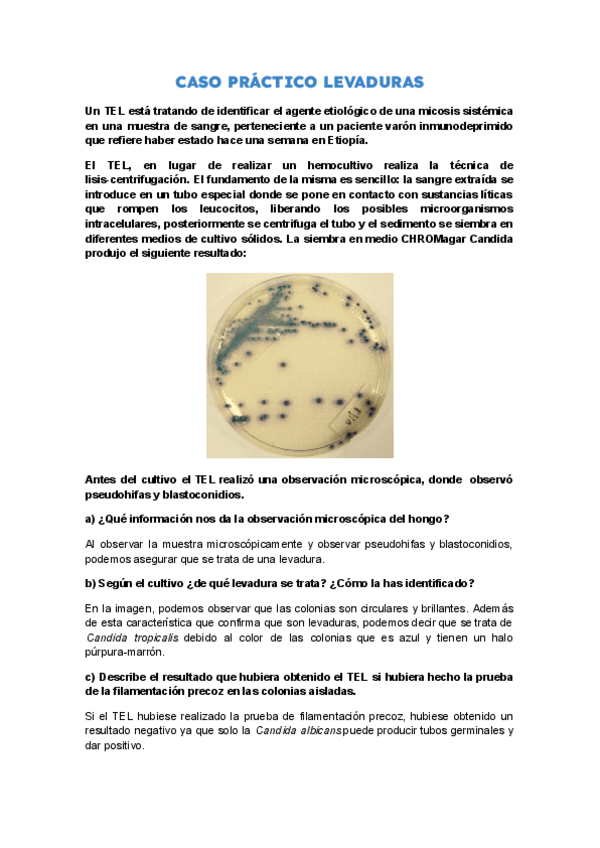

Sube tus apuntes
arrow_forwardAsignaturas de Aynadamar - Laboratorio Clínico y Biomédico
Asignatura
arrow_downward13 posts
9 posts
23 posts
13 posts
Últimas publicaciones de Aynadamar - Laboratorio Clínico y Biomédico
He publicado nuevos practicas de Técnicas generales de laboratorio: Cuaderno-de-practicas-TGL.pdf
He publicado nuevos practicas de Biología molecular y citogenética: CUADERNO-DE-PRACTICAS.pdf
He publicado nuevos practicas de Biología molecular y citogenética: CUADERNO-DE-PRACTICAS.pdf
He publicado nuevos apuntes de Biología molecular y citogenética: CUADERNO-DE-PRACTICAS-II.pdf
He publicado nuevos apuntes de Biología molecular y citogenética: CUADERNO-DE-PRACTICAS-I-PDF.pdf
He publicado nuevos practicas de Técnicas de análisis hematológico: CUADERNO-DE-PRACTICAS-Hema.pdf
He publicado nuevos practicas de Técnicas de análisis hematológico: CUADERNO-DE-PRACTICAS-Hema-Vol.-II.pdf
He publicado nuevos practicas de Técnicas de inmunodiagnóstico: Cuaderno-tecnicas-de-inmunodiagnostico.pdf
He publicado nuevos practicas de Biología molecular y citogenética: CUADERNO-DE-PRACTICAS-BMC.pdf
He publicado nuevos practicas de Técnicas generales de laboratorio: Cuaderno-de-practicas-TGL.pdf
He publicado nuevos trabajos de Proyecto de laboratorio clínico y biomédico: Deteccion-de-marcadores-tumorales-mediante-Western-blot.pdf
trabajos
-
Trabajos HLC 2ª EVALUACIÓN
He publicado nuevos trabajos de Microbiología clínica: Trabajos HLC 2ª EVALUACIÓN
trabajos
-
Trabajos HLC 1ª EVALUACIÓN
He publicado nuevos trabajos de Microbiología clínica: Trabajos HLC 1ª EVALUACIÓN
practicas
-
Prácticas
He publicado nuevos practicas de Microbiología clínica: Prácticas
practicas
-
Prácticas
He publicado nuevos practicas de Técnicas de inmunodiagnóstico: Prácticas
practicas
-
Prácticas
He publicado nuevos practicas de Análisis bioquímico: Prácticas
apuntes
-
Apuntes
He publicado nuevos apuntes de Análisis bioquímico: Apuntes
apuntes
-
Apuntes
He publicado nuevos apuntes de Técnicas de análisis hematológico: Apuntes
practicas
-
Prácticas
He publicado nuevos practicas de Técnicas de análisis hematológico: Prácticas
He publicado nuevos trabajos de Empresa e Iniciativa Emprendedora: proyecto-empresa.pdf
He publicado nuevos apuntes de Técnicas generales de laboratorio: CUADERNO-DE-PRACTICAS-PDF.pdf
He publicado nuevos apuntes de Técnicas de análisis hematológico: Esquemas-Hematologia-2o-trimestre.pdf
He publicado nuevos apuntes de Técnicas de análisis hematológico: Esquema-Cascada-coagulacion.pdf
He publicado nuevos apuntes de Análisis bioquímico: MAGNITUDES-PRODUCTOS-FINALES-DEL-METABOLISMO.pdf
He publicado nuevos apuntes de Análisis bioquímico: Esquemas-Enteros-Principios-Inmediatos.pdf
He publicado nuevos ejercicios de Gestión de muestras biológicas: ACTIVIDADES-GESTION-TEMA-11.docx
practicas
-
CUADERNO DE PRACTICAS 2º TRIMESTRE
He publicado nuevos practicas de Biología molecular y citogenética: CUADERNO DE PRACTICAS 2º TRIMESTRE
He publicado nuevos practicas de Técnicas generales de laboratorio: CUADERNO-VITUAL-DE-PRACTICAS-1.pdf
He publicado nuevos apuntes de Fisiopatología general: TEMA-11-FISIOPATOLOGIA-RESPIRATORIA.pdf
He publicado nuevos apuntes de Fisiopatología general: TEMA-10-PROCESO-DE-DESARROLLO-TUMORAL-II.pdf
He publicado nuevos apuntes de Fisiopatología general: TEMA-8-CARACTERISTICAS-DE-LAS-ENFERMEDADES-INFECCIOSAS.pdf
He publicado nuevos apuntes de Fisiopatología general: TEMA-7-TRASTORNOS-DEL-SISTEMA-INMUNITARIO.pdf
He publicado nuevos examenes de Proyecto de laboratorio clínico y biomédico: TFG-completo.pdf
practicas
-
practicas clase
He publicado nuevos practicas de Biología molecular y citogenética: practicas clase
apuntes
-
Protocolos cultivos celulares
He publicado nuevos apuntes de Biología molecular y citogenética: Protocolos cultivos celulares
apuntes
-
Apuntes cultivos celulares
He publicado nuevos apuntes de Biología molecular y citogenética: Apuntes cultivos celulares
apuntes
-
Trabajos cultivos celulares
He publicado nuevos apuntes de Biología molecular y citogenética: Trabajos cultivos celulares
apuntes
-
Trabajos Secuenciación
He publicado nuevos apuntes de Biología molecular y citogenética: Trabajos Secuenciación
apuntes
-
Exámenes
He publicado nuevos apuntes de Biología molecular y citogenética: Exámenes
apuntes
-
Citogenética
He publicado nuevos apuntes de Biología molecular y citogenética: Citogenética
apuntes
-
Trabajos citología
He publicado nuevos apuntes de Biología molecular y citogenética: Trabajos citología
apuntes
-
Exámenes
He publicado nuevos apuntes de Fisiopatología general: Exámenes
apuntes
-
Apuntes Alfredo
He publicado nuevos apuntes de Fisiopatología general: Apuntes Alfredo
trabajos
-
Actividades HLC
He publicado nuevos trabajos de Microbiología clínica: Actividades HLC
practicas
-
practicas todo el curso
He publicado nuevos practicas de Técnicas de inmunodiagnóstico: practicas todo el curso
practicas
-
practicas microbiología todo el curso
He publicado nuevos practicas de Microbiología clínica: practicas microbiología todo el curso